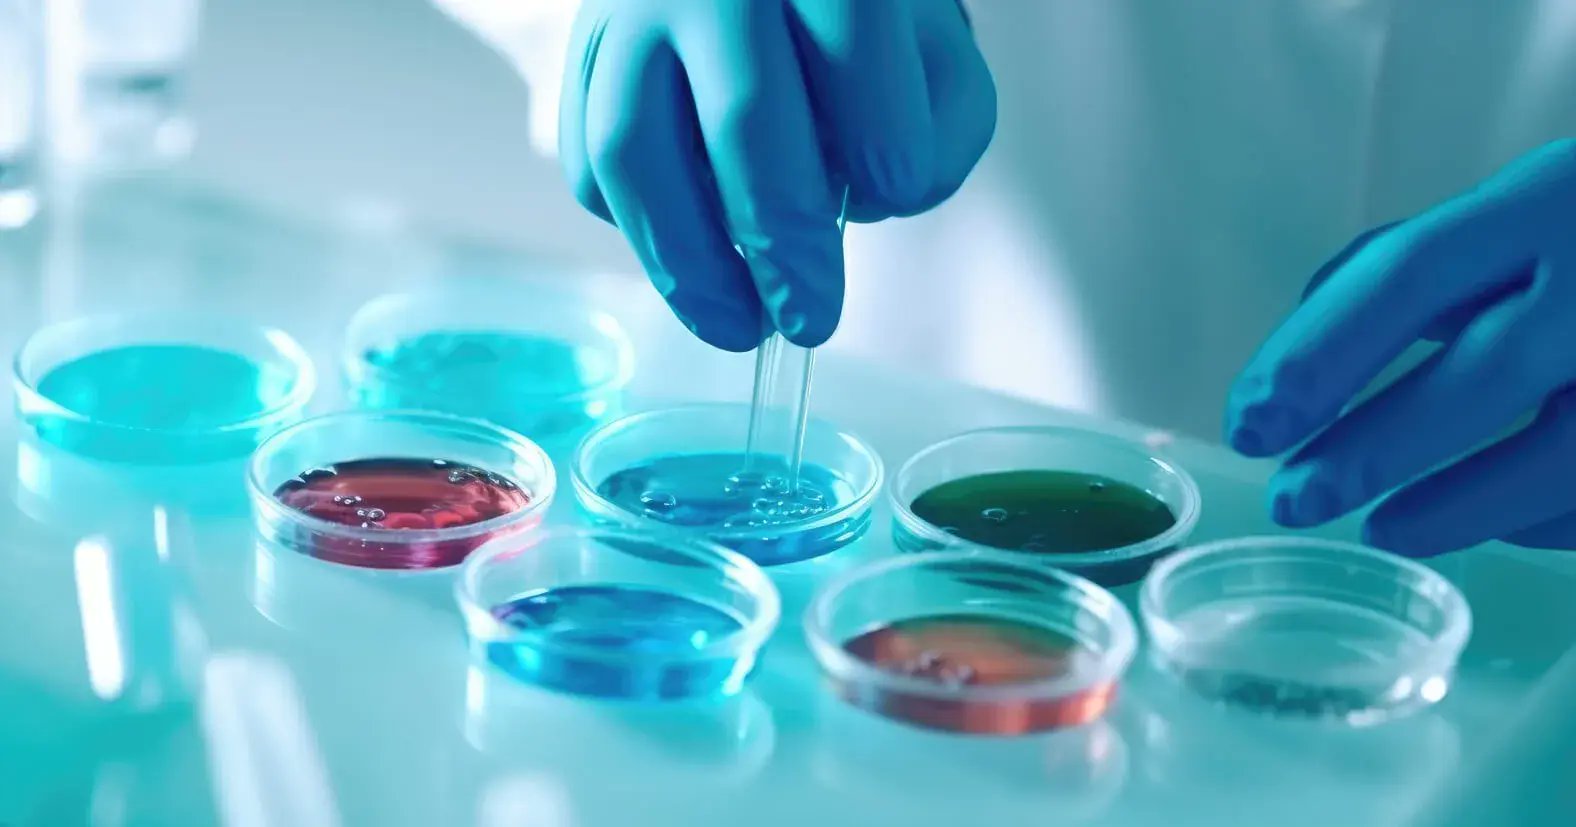
AutomateTech's tweet card. This guide delves into biotech startups, exploring the driving forces behind their rise and projecting the trends that will shape their trajectory.

Automate Technology
@AutomateTech
Making IT Work! Providing bespoke IT sales & support soltions for SMEs in Ireland.
Was dir gefallen könnte
AI is a key technology for NASA, from autonomous rovers on Mars that navigate with machine learning to systems that analyze satellite data. A look at how AI powers space exploration. #NASA #SpaceTech #AI #Science nasa.gov/artificial-int…
nasa.gov
Artificial Intelligence - NASA
Artificial intelligence helps us support missions and research projects across the agency, analyze data to reveal trends and patterns, and develop systems
A new Gallup poll shows trust in businesses to use AI responsibly is up slightly, but a majority still worry about its impact on jobs and society. Where do you land on AI's infiltration into all corners of business? #BigTech #Gallup #PublicOpinion #AI #Te news.gallup.com/poll/694688/tr…
Tool overwhelm' is real. It's easy to get caught up chasing maximum productivity, and just as easy to fall into the trap of using too many tools. Especially now that you've got AI tools to help you use your other AI tools. Even the 'standard' apps can become too much. Sla

A deep dive into the security and privacy vulnerabilities of smart home devices powered by AI. Learn how to protect your connected home as new technology emerges. #SmartHome #Privacy #Cybersecurity #HelpNetSecurity helpnetsecurity.com/2025/08/26/llm…
Lenovo's new Legion Go 2 gaming handheld gets powerful upgrades and a bigger battery, but it comes with a significantly higher price tag. Is it worth the cost? #Lenovo #GamingTech #Hardware #TechReview #Handheld engadget.com/gaming/pc/leno…
Is dollar store tech a hidden gem or a waste of money? This CNET review of 10 bargain gadgets finds some surprising hits among the misses. #Gadgets #ConsumerTech #PCWorld #TechReview cnet.com/home/is-dollar…
A new era of ransomware attacks is targeting cloud infrastructure. What are the key vulnerabilities and how can businesses protect their data? #Ransomware #Cybersecurity #CloudSecurity #MSSPAlert bleepingcomputer.com/news/security/…
The future of work is here, and it's powered by AI. A look at how companies are leveraging AI tools to enhance productivity and collaboration. #FutureOfWork #AI #BusinessStrategy #Forbes forbes.com/sites/sap/2025…
Your Multi-Factor Authentication might be a security risk. You probably feel safer knowing your accounts are protected by Multi-Factor Authentication. And you should. It’s a big step up from using passwords alone, but here’s the problem most people don't realize… hackers h




Meta's new AI glasses can read messages and translate conversations right on the lens. Is this a step forward for AR, or does it raise new privacy concerns? #VR #AugmentedReality #TechTrends #TheVerge news.sky.com/video/metas-ai…
Think all Amazon reviews are trustworthy? Think again. Here's how to tell if that 5-star rating is legit or just clever marketing. #AmazonTips #ReviewScams #SmartShopping pcmag.com/how-to/dont-ge…
New EU regulations on financial data sharing may block US tech giants from accessing consumer information. What does this mean for data collection and consumer choice as a whole? #DataPrivacy #EU #Regulation #Geopolitics techradar.com/pro/eu-plans-t…
Biotech startups are redefining innovation in 2025. From AI-driven diagnostics to sustainable bioproducts, this new era is reshaping healthcare and the environment. Dive into the trends driving this transformation. #Biotech #Innovation #Healthcare #Sustai councils.forbes.com/blog/the-boom-…
New phishing campaigns are using "Contact Us" forms and fake NDAs to target companies, including small businesses. Learn how to protect your firm from these advanced social engineering attacks. #SMB #Cybersecurity #Phishing #BusinessSecurity helpnetsecurity.com/2025/08/29/phi…
Apple's new iPhone Air is incredibly thin and stylish, but what did they have to sacrifice to make it so sleek? Heres a hands-on review to see if the design is worth the cost. #iPhoneAir #Apple #TechReview #MobileTech #CNET cnet.com/videos/iphone-…

cnet.com
iPhone Air Review: A Joy to Hold, at a Cost - Video
Is your team ready for the next-gen cloud workspace? Windows 365 now delivers smarter, more resilient AI-powered Cloud PCs with enhanced security. Discover what's new in this game-changing update. #CloudComputing #AIWorkplace #DigitalTransformation blogs.windows.com/windowsexperie…
Cybercriminals are using sophisticated attacks, including deepfakes, to target law firms and steal sensitive client data. Learn how to protect against these new growing threats. #Cybersecurity #AI #Deepfakes #BusinessSecurity helpnetsecurity.com/2025/09/23/law…
Looking for a new laptop? The latest models are smarter than ever with powerful AI features. Check out the best laptops of 2025 to find your perfect match! #Laptops #TechReview #AI #ConsumerTech #PCMag pcmag.com/picks/the-best…
Private companies are selling powerful spyware to governments that can infect your device without you even knowing and monitor everything you do. It's a complex topic, but this article breaks it down very well. #Spyware #Privacy #CyberSecurity #Tech gbhackers.com/commercial-spy…
Two AI coding assistants accidentally wiped user code using hallucination logic. Reminder: AI can be helpful, but stay alert when it "thinks" for you. #AICoding #StayVigilant #DevTools arstechnica.com/information-te…
United States Trends
- 1. Peggy 32.6K posts
- 2. Sonic 06 2,483 posts
- 3. $SENS $0.70 Senseonics CGM N/A
- 4. Berseria 4,961 posts
- 5. Zeraora 15K posts
- 6. $APDN $0.20 Applied DNA N/A
- 7. $LMT $450.50 Lockheed F-35 N/A
- 8. Cory Mills 30.4K posts
- 9. #ComunaONada 3,592 posts
- 10. Randy Jones 1,010 posts
- 11. $NVDA 45.1K posts
- 12. Cooks 10.1K posts
- 13. Dearborn 381K posts
- 14. #Stargate N/A
- 15. Ryan Wedding 4,739 posts
- 16. Rick Hendrick 1,211 posts
- 17. International Men's Day 86.3K posts
- 18. Comey 38.2K posts
- 19. Saudi Investment Forum 3,952 posts
- 20. #CurrysPurpleFriday 13.7K posts
Was dir gefallen könnte
Something went wrong.
Something went wrong.